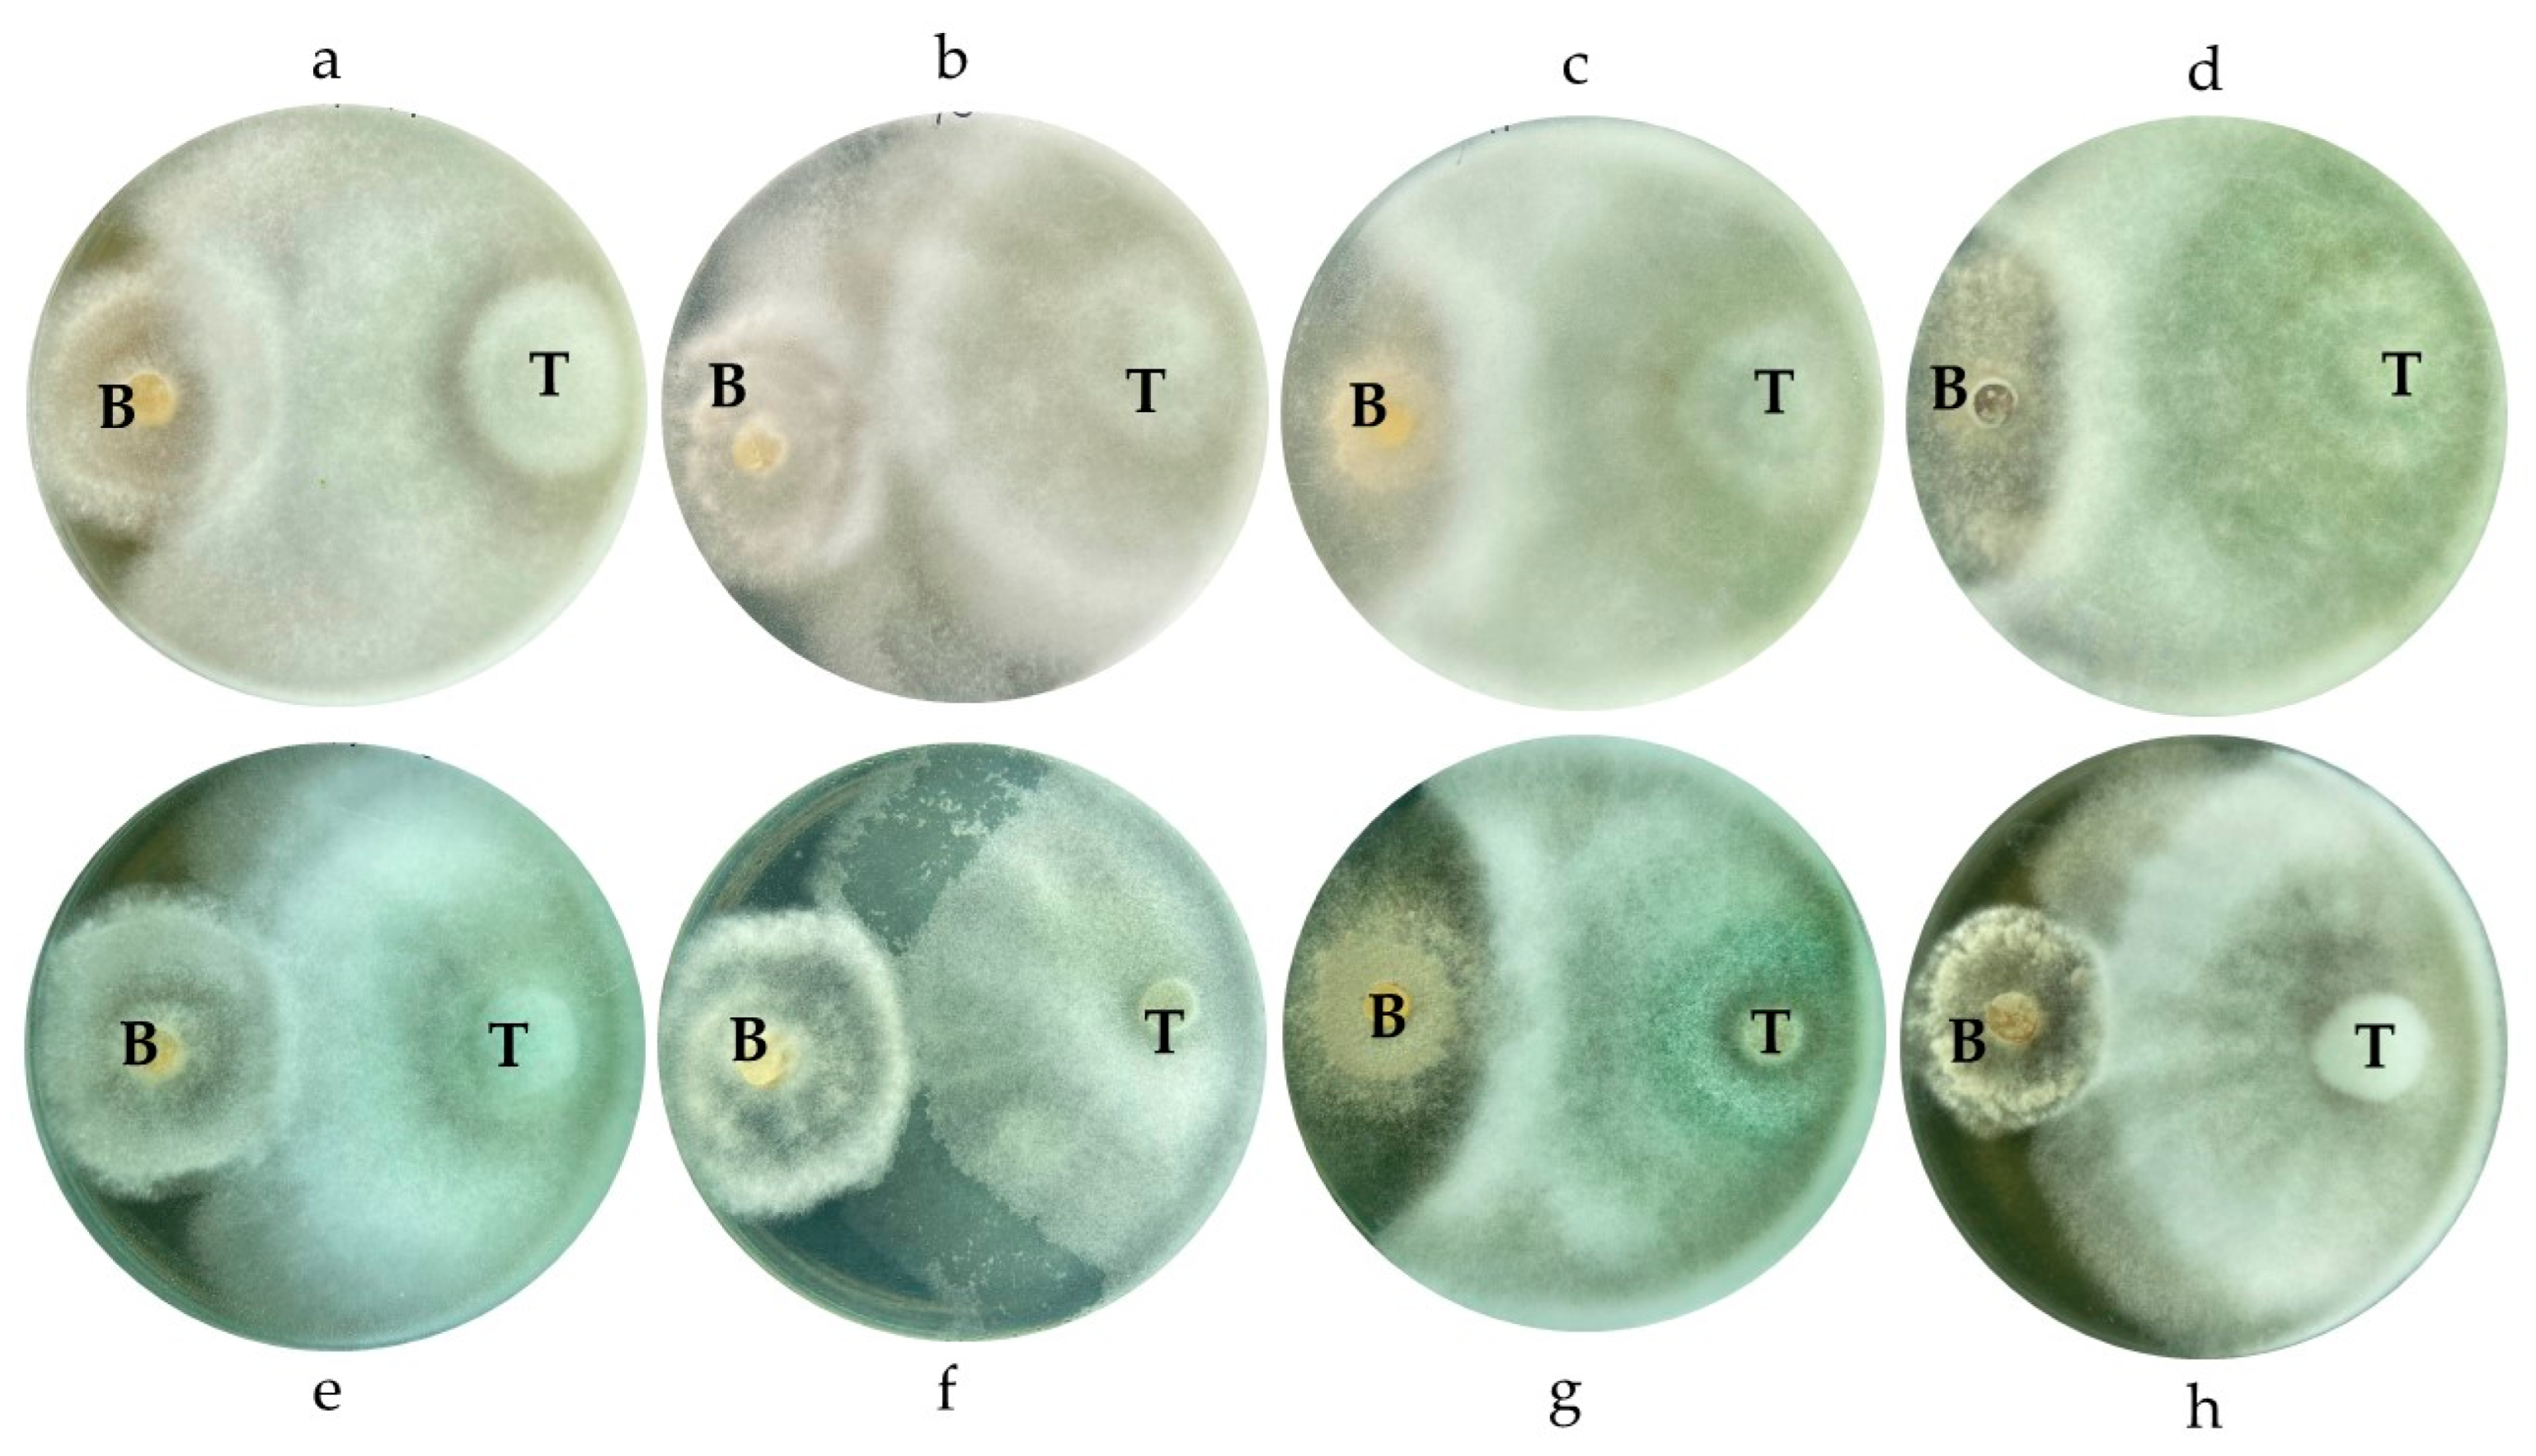
Horticulturae 11 00725 g013

Identification of Botrytis cinerea as a Walnut Fruit Rot Pathogen, and Its Biocontrol by Trichoderma
Abstract
1. Introduction
2. Materials and Methods
2.1. Origin and Description of Plant Samples
2.2. ONFIT Assay
2.3. Morphological and Molecular Characterization of Fungal Isolates
2.4. Determination of Optimal Growth Temperatures for Botrytis cinerea Isolates
2.5. Pathogenicity Test
2.6. Dual Culture Test of Botrytis cinerea and Trichoderma spp.
2.7. Statistical Analysis
3. Results
3.1. Assessment of Symptoms of Immature Walnuts
3.2. ONFIT Assay Results
3.3. Morphological and Molecular Characterization of Casual Pathogens
3.4. Temperature Growth Profiles of Botrytis cinerea Isolates
3.5. Pathogenicity Test
3.6. Dual Culture of Botrytis cinerea and Trichoderma spp.
4. Discussion
5. Conclusions
Author Contributions
Funding
Data Availability Statement
Acknowledgments
Conflicts of Interest
Abbreviations
| ONFIT | Overnight Freezing-Incubation Technique |
| PDA | Potato Dextrose Agar |
| ITS | Internal Transcribed Spacer |
| PCR | Polymerase Chain Reaction |
| BLAST | Basic Local Alignment Search Tool |
| NCBI | National Center for Biotechnology Information |
| MEGA | Molecular Evolutionary Genetics Analysis |
| BBCH | Biologische Bundesanstalt Bundessortenamt CHemical industry |
| CLD | Compact Letter Display |
| rDNA | Rribosomal DNA |
| SE | Standard Error |
References
- Vahdati, K.; Arab, M.M.; Sarikhani, S.; Sadat-Hosseini, M.; Leslie, C.A.; Brown, P.J. Advances in Persian Walnut (Juglans regia L.) Breeding Strategies. In Advances in Plant Breeding Strategies: Nut and Beverage Crops; Al-Khayri, J.M., Jain, S.M., Johnson, D.V., Eds.; Springer Nature Switzerland AG: Cham, Switzerland, 2019; Volume 4, pp. 401–472. [Google Scholar]
- FAO. Food and Agriculture Organization of the United Nations. Data and Statistics for Walnut. Available online: https://www.fao.org/faostat/en/#data/QCL (accessed on 21 March 2025).
- Chen, S.F.; Morgan, D.P.; Hasey, J.K.; Anderson, K.; Michailides, T.J. Phylogeny, morphology, distribution, and pathogenicity of Botryosphaeriaceae and Diaporthaceae from English walnut in California. Plant Dis. 2014, 98, 636–652. [Google Scholar] [CrossRef] [PubMed]
- Meng, L.; Yu, C.; Wang, C.; Li, G. First Report of Diaporthe amygdali Causing walnut twig canker in Shandong Province of China. Plant Dis. 2018, 102, 1859. [Google Scholar] [CrossRef]
- Moral, J.; Morgan, D.; Trapero, A.; Michailides, T.J. Ecology and epidemiology of diseases of nut crops and olives diseases caused by Botryosphaeriaceae fungi in California and Spain. Plant Dis. 2019, 103, 1809–1827. [Google Scholar] [CrossRef] [PubMed]
- Zabiák, A.; Kovács, C.; Takács, F.; Pál, K.; Peles, F.; Fekete, E.; Karaffa, L.; Mihály, K.; Flipphi, M.; Sándor, E. Diaporthe and Diplodia Species Associated with Walnut (Juglans regia L.) in Hungarian Orchards. Horticulturae 2023, 9, 205. [Google Scholar] [CrossRef]
- Zabiák, A.; Csótó, A.; Tóth, B.; Takács, F.; Pál, K.; Sándor, E. Identification of Botryosphaeria dothidea and Diaporthe eres from rotted walnut fruits and other plant parts in different phenological stages. Acta Phytopathol. Entomol. Hung. 2023, 58, 218–237. [Google Scholar] [CrossRef]
- Spence, L.A.; Henschel, B.; Li, R.; Tekwe, C.D.; Thiagarajah, K. Adding Walnuts to the Usual Diet Can Improve Diet Quality in the United States: Diet Modeling Study Based on NHANES 2015–2018. Nutrients 2023, 15, 258. [Google Scholar] [CrossRef]
- Mulrean, E.N.; Schroth, M.N. Ecology of Xanthomonas campestris pv. juglandis on Persian (English) walnuts. Phytopathology 1982, 72, 434–438. [Google Scholar] [CrossRef]
- Zhang, Q.; Kang, M.; Zhao, R.; Song, L.; Ji, X.; He, A.; Ji, Y. Analysis of the diversity of fungi on green walnut surface based on high-throughput sequencing. Storage Process 2024, 8, 102–108. [Google Scholar]
- Varjas, V.; Lakatos, T.; Tóth, T.; Kovács, C. First report of Colletotrichum godetiae causing anthracnose and twig blight on Persian walnut in Hungary. Plant Dis. 2020, 105, 702. [Google Scholar] [CrossRef]
- Li, F.; Chen, J.; Chen, Q.; Liu, Z.; Sun, J.; Yan, Y.; Zhang, H.; Bi, Y. Identification, pathogenicity, and sensitivity to fungicide of Colletotrichum species that causes walnut anthracnose in Beijing. Agronomy 2023, 13, 214. [Google Scholar] [CrossRef]
- Zhang, Q.Q.; Shi, J.; Shen, P.Y.; Xi, F.; Qian, C.Y.; Zhang, G.H.; Zhu, H.J.; Xiao, H.M. Exploring the efficacy of biocontrol microbes against the fungal pathogen Botryosphaeria dothidea JNHT01 isolated from fresh walnut fruit. Foods 2022, 11, 3651. [Google Scholar] [CrossRef] [PubMed]
- Çakar, D. Role of the fungal flora on kernel rot of chestnuts. Uluslararası Tarım Yaban Hayatı Bilim. Derg. 2023, 9, 143–152. [Google Scholar] [CrossRef]
- Sun, J.; Zhang, X.; Zheng, J.; Liu, G.; Chen, L. Importance of cell wall permeability and cell wall degrading enzymes during infection of Botrytis cinerea in hazelnut. Forests 2023, 14, 565. [Google Scholar] [CrossRef]
- Zheng, X.R.; Huang, X.X.; Peng, J.F.; Gafforov, Y.; Chen, J.J. Occurrence of Botrytis cinerea causing gray mold on pecan in China. Horticulturae 2024, 10, 1212. [Google Scholar] [CrossRef]
- Fedele, G.; González-Domínguez, E.; Rossi, V. Influence of Environment on the Biocontrol of Botrytis cinerea: A Systematic Literature Review. In How Research Can Stimulate the Development of Commercial Biological Control Against Plant Diseases, Progress in Biological Control; De Cal, A., Melgarejo, P., Magan, N., Eds.; Springer: Cham, Switzerland, 2020; Volume 21, pp. 61–82. [Google Scholar]
- Hamond, J.B. Ann. Rept. East Malling Rex. Stat. 1928, 1929 and 1930, II Supplement, 1931, pp. 143–149 In: CABI Digital Library. Available online: https://www.cabidigitallibrary.org/doi/full/10.5555/19321100165 (accessed on 21 March 2025).
- Braithwaite, L.; Braithwaite, M. Walnut Kernel Mould: Linking Canterbury Research to the Published Scientific Literature; Plant Diagnostics Limited: Templeton, Christchurch, 2020; Available online: https://walnuts.org.nz/wp-content/uploads/2020/11/Walnut-kernel-decay-review-Final-110920-1.pdf (accessed on 21 March 2025).
- Fillinger, S.; Elad, Y. Botrytis—The Fungus, The Pathogen and Its Management in Agricultural Systems; Springer International Publishing: Cham, Switzerland, 2016. [Google Scholar]
- Fernández-Ortuño, D.; Grabke, A.; Li, X.P.; Schnabel, G. Independent emergence of resistance to seven chemical classes of fungicides in Botrytis cinerea. Phytopathology 2015, 105, 424–432. [Google Scholar] [CrossRef]
- Druzhinina, I.S.; Chenthamara, K.; Zhang, J.; Atanasova, L.; Yang, D.; Miao, Y.; Rahimi, M.J.; Grujic, M.; Cai, F.; Pourmehdi, S.; et al. Massive lateral transfer of genes encoding plant cell wall-degrading enzymes to the mycoparasitic fungus Trichoderma from its plant-associated hosts. PLoS Genet. 2018, 14, e1007322. [Google Scholar] [CrossRef]
- Tyśkiewicz, R.; Nowak, A.; Ozimek, E.; Jaroszuk-Ściseł, J. Trichoderma: The current status of its application in agriculture for the biocontrol of fungal phytopathogens and stimulation of plant growth. Int. J. Mol. Sci. 2022, 23, 2329. [Google Scholar] [CrossRef]
- Csótó, A.; Kovács, C.; Pál, K.; Nagy, A.; Peles, F.; Fekete, E.; Karaffa, L.; Kubicek, C.P.; Sándor, E. The biocontrol potential of endophytic Trichoderma fungi isolated from Hungarian grapevines, Part II, Grapevine stimulation. Pathogens 2023, 12, 2. [Google Scholar] [CrossRef]
- Michailides, T.J.; Morgan, D.P.; Felts, D. Detection and significance of symptomless latent infection of Monilinia fructicola in California stone fruits. Phytopathology 2000, 90, S53. [Google Scholar]
- Michailides, T.J.; Morgan, D.P.; Luo, Y. Epidemiological Assessments and Postharvest Disease Incidence. In Postharvest Pathology. Plant Pathology in the 21st Century (Contributions to the 9th International Congress); Prusky, D., Gullino, M., Eds.; Springer: Dordrecht, The Netherlands, 2009; Volume 2. [Google Scholar] [CrossRef]
- Kovács, C.; Peles, F.; Bihari, Z.; Sándor, E. Endophytic fungi associated with Grapevine Trunk Diseases, from Tokaj wine region, Hungary. Növényvédelem 2014, 50, 153–159. [Google Scholar]
- Pezet, R.; Viret, O.; Perret, C.; Tabacchi, R. Latency of Botrytis cinerea Pers.: Fr. and biochemical studies during growth and ripening of two grape berry cultivars, respectively susceptible and resistant to grey mould. J. Phytopathol. 2003, 151, 208–214. [Google Scholar] [CrossRef]
- Thi Minh Le, T.; Thi Hong Hoang, A.; Thi Bich Le, T.; Thi Bich Vo, T.; Van Quyen, D.; Hoang Chu, H. Isolation of endophytic fungi and screening of Huperzine A–producing fungus from Huperzia serrata in Vietnam. Sci. Rep. 2019, 9, 16152. [Google Scholar] [CrossRef] [PubMed]
- White, T.J.; Bruns, T.; Lee, S.; Taylor, J.W. PCR Protocols: A Guide to Methods and Applications; Academic Press: New York, NY, USA, 1990; p. 482. [Google Scholar]
- Kumar, S.; Stecher, G.; Tamura, K. MEGA7: Molecular Evolutionary Genetics Analysis version 7.0 for bigger datasets. Mol. Biol. Evol. 2016, 33, 1870–1874. [Google Scholar] [CrossRef]
- Kimura, M. A simple method for estimating evolutionary rate of base substitutions through comparative studies of nucleotide sequences. J. Mol. Evol. 1980, 16, 111–120. [Google Scholar] [CrossRef]
- Robin, J.; Bernard, A.; Albouy, L.; Papillon, S.; Tranchand, E.; Hebrard, M.N.; Philibert, J.B.; Barbedette, M.; Schafleitner, S.; Wenden, B.; et al. Description of Phenological Events of Persian Walnut (Juglans regia L.) according to the Extended BBCH Scale and Historical Scales. Horticulturae 2024, 10, 402. [Google Scholar] [CrossRef]
- McKinney, H.H. Influence of soil temperature and moisture on infection of wheat seedlings by Helmintosporium sativum. J. Agric. Res. 1923, 26, 195–218. [Google Scholar]
- Lamichhane, J.R. Xanthomonas arboricola Diseases of Stone Fruit, Almond, and Walnut Trees: Progress Toward Understanding and Management. Plant Dis. 2014, 98, 1600–1610. [Google Scholar] [CrossRef]
- Garfinkel, A.R.; Coats, K.P.; Sherry, D.L.; Chastagner, G.A. Genetic Analysis Reveals Unprecedented Diversity of a Globally-Important Plant Pathogenic Genus. Sci. Rep. 2019, 9, 6671. [Google Scholar] [CrossRef]
- Dučkena, L.; Bimšteine, G.; Bankina, B.; Skinderskis, E.; Roga, A.; Frīdmanis, D. Morphological diversity and mycelial compatibility of Botrytis pseudocinerea and Botrytis cinerea isolated in Latvia. Proc. Latv. Acad. Sci. 2024, 78, 197–205. [Google Scholar] [CrossRef]
- Fekete, É.; Fekete, E.; Irinyi, L.; Karaffa, L.; Árnyasi, M.; Asadollahi, M.; Sándor, E. Genetic diversity of a Botrytis cinerea cryptic species complex in Hungary. Microbiol. Res. 2012, 167, 283–291. [Google Scholar] [CrossRef]
- Staats, M.; van Baarlen, P.; van Kan, J.A.L. Molecular phylogeny of the plant pathogenic genus Botrytis and the evolution of host specificity. Mol. Biol. Evol. 2005, 22, 333–346. [Google Scholar] [CrossRef] [PubMed]
- Lukasko, N.T.; Hausbeck, M.K. Whole-genome resource of seven Botrytis cinerea sensu lato isolates with resistance or sensitivity to seven site-specific fungicides. Phyto Front. 2024, 4, 251–254. [Google Scholar] [CrossRef]
- Dean, R.; Van Kan, J.A.; Pretorius, Z.A.; Hammond-Kosack, K.E.; Di Pietro, A.; Spanu, P.D.; Rudd, J.J.; Dickman, M.; Kahmann, R.; Ellis, J.; et al. The Top 10 fungal pathogens in molecular plant pathology. Mol. Plant Pathol. 2012, 13, 414–430. [Google Scholar] [CrossRef] [PubMed]
- Elad, Y.; Pertot, I.; Cotes Prado, A.M.; Stewart, A. Plant Hosts of Botrytis spp. In Botrytis—The Fungus, the Pathogen and Its Management in Agricultural Systems; Fillinger, S., Elad, Y., Eds.; Springer: Cham, Switzerland, 2016; pp. 1–15. [Google Scholar] [CrossRef]
- Pande, S.; Galloway, J.; Gaur, P.M.; Siddique, K.H.M.; Tripathi, H.S.; Taylor, P.; MacLeod, M.W.J.; Basandrai, A.K.; Bakr, A.; Joshi, S.; et al. Botrytis grey mould of chickpea: A review of biology, epidemiology, and disease management. Aust. J. Agric. Res. 2006, 57, 1137–1150. [Google Scholar] [CrossRef]
- Droby, S.; Lichter, A. Post-Harvest Botrytis Infection: Etiology, Development and Management. In Botrytis: Biology, Pathology and Control; Elad, Y., Williamson, B., Tudzynski, P., Delen, N., Eds.; Springer: Dordrecht, The Netherlands, 2007; pp. 349–367. [Google Scholar] [CrossRef]
- Williamson, B.; Tudzynski, B.; Tudzynski, P.; van Kan, J.A.L. Botrytis cinerea: The cause of grey mould disease. Mol. Plant Pathol. 2007, 8, 561–580. [Google Scholar] [CrossRef]
- Kuroyanagi, T.; Bulasag, A.S.; Fukushima, K.; Ashida, A.; Suzuki, T.; Tanaka, A.; Camagna, M.; Sato, I.; Chiba, S.; Ojika, M.; et al. Botrytis cinerea identifies host plants via the recognition of antifungal capsidiol to induce expression of a specific detoxification gene. PNAS Nexus 2022, 1, pgac274. [Google Scholar] [CrossRef]
- Silva, C.J.; Adaskaveg, J.A.; Mesquida-Pesci, S.D.; Ortega-Salazar, I.B.; Pattathil, S.; Zhang, L.; Hahn, M.G.; van Kan, J.A.L.; Cantu, D.; Powell, A.L.T.; et al. Botrytis cinerea infection accelerates ripening and cell wall disassembly to promote disease in tomato fruit. Plant Physiol. 2023, 191, 575–590. [Google Scholar] [CrossRef]
- Wu, Z.; Gao, T.; Liang, Z.; Hao, J.; Liu, P.; Liu, X. Dynamic changes in plant secondary metabolites induced by Botrytis cinerea infection. Metabolites 2023, 13, 654. [Google Scholar] [CrossRef]
- Widiastuti, A.; Yoshino, M.; Saito, H.; Maejima, K.; Zhou, S.; Odani, H.; Hasegawa, M.; Nitta, Y.; Sato, T. Induction of disease resistance against Botrytis cinerea by heat shock treatment in melon (Cucumis melo L.). Physiol. Mol. Plant Pathol. 2011, 75, 157–162. [Google Scholar] [CrossRef]
- Zhang, M.; Trushina, N.K.; Lang, T.; Hahn, M.; Pasmanik-Chor, M.; Sharon, A. Serine peptidases and increased amounts of soluble proteins contribute to heat priming of the plant pathogenic fungus Botrytis cinerea. mBio 2023, 14, e0107723. [Google Scholar] [CrossRef]
- Hungarian Meteorological Service. Temperature in Hungary. HungaroMet. Available online: https://www.met.hu/en/eghajlat/magyarorszag_eghajlata/altalanos_eghajlati_jellemzes/homerseklet/ (accessed on 12 October 2024).
- Geng, L.; Fu, Y.; Peng, X.; Yang, Z.; Zhang, M.; Song, Z.; Guo, N.; Chen, S.; Chen, J.; Bai, B.; et al. Biocontrol potential of Trichoderma harzianum against Botrytis cinerea in tomato plants. Biol. Control 2022, 174, 105019. [Google Scholar] [CrossRef]
- Kovács, C.; Csótó, A.; Pál, K.; Nagy, A.; Fekete, E.; Karaffa, L.; Kubicek, C.P.; Sándor, E. The biocontrol potential of endophytic Trichoderma fungi isolated from Hungarian grapevines. Part I. Isolation, identification and in vitro studies. Pathogens 2021, 10, 1612. [Google Scholar] [CrossRef]

| Date | Active Ingredient | Dose (g/ha) |
|---|---|---|
| 20 March 2023 | CuOCl + S | 1595 + 4000 |
| 28 April 2023 | tebuconazole | 180 |
| 12 May 2023 | tebuconazole | 250 |
| 1 June 2023 | CuOCl + S | 1595 + 4000 |
| Genus | Number of Infected Fruits |
|---|---|
| Aspergillus | 19 |
| Botryosphaeria | 2 |
| Botrytis | 37 |
| Fusarium | 2 |
| Penicillium | 19 |
| Diaporthe | 1 |
| Isolate | Accession Number |
|---|---|
| J5008 | PV290581 |
| J509/2 | PV290582 |
| J5011/1 | PV290583 |
| J5013/3 | PV290584 |
| J5018 | PV290585 |
| J5021 | PV290586 |
| J5017 | PV290587 |
| J5012 | PV290588 |
| Isolate | Colony Diameter (mm, Mean + SE) |
|---|---|
| J5011/1 | 71.6 ± 7.88 |
| J5013/3 | 16.0 ± 16.00 |
| J5017 | 81.2 ± 6.60 |
| J5021 | 42.0 ± 17.38 |
Disclaimer/Publisher’s Note: The statements, opinions and data contained in all publications are solely those of the individual author(s) and contributor(s) and not of MDPI and/or the editor(s). MDPI and/or the editor(s) disclaim responsibility for any injury to people or property resulting from any ideas, methods, instructions or products referred to in the content. |
© 2025 by the authors. Licensee MDPI, Basel, Switzerland. This article is an open access article distributed under the terms and conditions of the Creative Commons Attribution (CC BY) license (https://creativecommons.org/licenses/by/4.0/).
Share and Cite
Zabiák, A.; Csótó, A.; Pál, K.; Fekete, E.; Karaffa, L.; Sándor, E. Identification of Botrytis cinerea as a Walnut Fruit Rot Pathogen, and Its Biocontrol by Trichoderma. Horticulturae 2025, 11, 725. https://doi.org/10.3390/horticulturae11070725
Zabiák A, Csótó A, Pál K, Fekete E, Karaffa L, Sándor E. Identification of Botrytis cinerea as a Walnut Fruit Rot Pathogen, and Its Biocontrol by Trichoderma. Horticulturae. 2025; 11(7):725. https://doi.org/10.3390/horticulturae11070725
Chicago/Turabian StyleZabiák, Andrea, András Csótó, Károly Pál, Erzsébet Fekete, Levente Karaffa, and Erzsébet Sándor. 2025. "Identification of Botrytis cinerea as a Walnut Fruit Rot Pathogen, and Its Biocontrol by Trichoderma" Horticulturae 11, no. 7: 725. https://doi.org/10.3390/horticulturae11070725
APA StyleZabiák, A., Csótó, A., Pál, K., Fekete, E., Karaffa, L., & Sándor, E. (2025). Identification of Botrytis cinerea as a Walnut Fruit Rot Pathogen, and Its Biocontrol by Trichoderma. Horticulturae, 11(7), 725. https://doi.org/10.3390/horticulturae11070725








